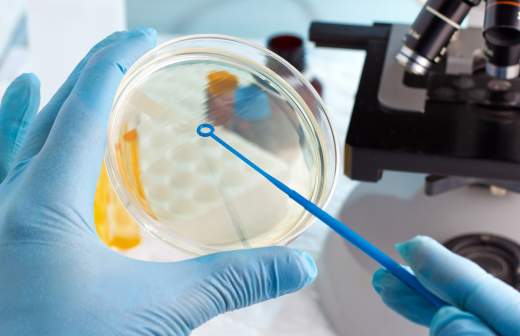

Вирусолог назвал опасность «южноафриканского» штамма коронавируса

«Южноафриканский» штамм коронавируса опаснее «британского»: он приобретает мутации для повторного заражения людей, рассказал в интервью «Известиям» вирусолог, руководитель лаборатории геномной инженерии МФТИ Павел Волчков. По его словам, такой вариант SARS-CoV-2 приобрел мутации, которые делают его менее заметными для иммунной системы человека.
И «британский», и «южноафриканский» штаммы коронавируса принадлежат к одной группе, указал Павел Волчков. Но «южноафриканский» вариант приобрел еще несколько мутаций по отношению к «британскому», которые помогли ему уходить от моноклональных антител (скопированных с природных и размноженных в пробирке антител. Они применяются как лекарства и для исследований).
«Это доказательство того, что патоген научился уходить от иммунитета. Моноклональные антитела — это выделенные от человека факторы защиты, которые ученые сейчас часто используют в исследованиях. Они продаются для использования в лабораториях для научной деятельности. Эти нейтрализующие антитела умеют очень хорошо связывать (препятствовать проникновению SARS-CoV-2 в клетку. — «Известия») тот самый первоначальный «уханьский» вирус. Ученые недавно доказали, что эти антитела действовали на «уханьский» вариант, а на «южноафриканский» уже не действуют. Это значит, что в организме они тоже не смогут его нейтрализовать», — объяснил Павел Волчков.
Таким образом, мутирующий вирус начинает преодолевать адаптивный иммунитет. И эти изменения дадут ему возможность инфицировать уже переболевших, так как у них в организмах содержатся антитела к предыдущему, еще немутировавшему штамму, добавил вирусолог.
По его словам, такой вариант SARS-CoV-2 появился из-за того, что для лечения пациентов применяется плазма с антителами переболевших. Это послужило причиной эволюционного давления и отбора тех коронавирусов, которые научились уходить от такой защиты.
Подробнее читайте в эксклюзивном интервью «Известиям»:
«Южноафриканский» штамм точно хуже «британского»